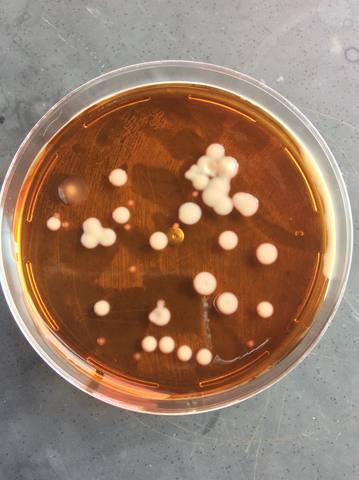
Aislamiento de Streptococcus mutans a partir de muestras tomadas de cepillos de dientes usados

-
De primero a quinto estudie la primaria en el Instituto Profesional en la Enseñanza y Formación Humana (IPEFH)
-
El sexto año de primaria me cambie de escuela, y acabe la primaria en el Colegio Vilaseca de Toluca
-
Realice mis estudios en la Escuela Secundaria Oficial No. 0005 Anexa a la ENSEM
-
Inicie el bachillerato en el Instituto Tecnológico y de Estudios Superiores de Monterrey Campus Toluca
-
Voluntariado en el Albergue Belen
-
Voluntariado al albergue infantil Monica Pretelini
-
Experiencia retadora, en la que desarrolle competencias para la vida real aportando conocimiento y liderazgo para solucionar problemáticas actuales, trabajando en colaboración con estudiantes de diferentes carreras
-
Inicio la carrera de Ingeniero en Biotecnología en el Tecnológico de Monterrey Campus Toluca
-
Proyecto en equipo el cual se investigo una micro alga llamada Espirulina para realizar barras proteicas
-
Graduación de preparatoria
-
Mi semana i la realice en Puebla, la cual consistía en crear un evento para recaudar fondo y ayudar a las personas afectadas por el terremoto del 19 de Septiembre de 2016. Este evento se realizo en equipo y con estudiantes de diferentes campus.
-
Impartí clases de química experimental con alumnos de secundaria. En la cual se realizaron dos tipos de practicas de laboratorio con apoyo de la escuela. Esto se realizo con dos escuelas diferentes, en donde una era publica y la otra era privada.
-
Curso de hidroponia urbana para cultivos de autoconsumo. Este curso lo tome en San Luis Potosí.
-
Proyecto que se realizó con personas de diferentes estados de la
República Mexicana, la cual tenía como propósito generar una semana con bajo impacto global y sensibilizar a la sociedad. Esta semana se llevo en dos estados diferentes (Querétaro y San Luis Potosí) -
Proyecto realizado en equipo, laboratorios de Tecnológico de
Monterrey Campus Toluca. Consistía en lograr el aislamiento de esta bacteria a partir de los cepillos de dientes e incubarla para realizar pruebas bioquímicas . -
Intercambio internacional a Alemania o Canadá para incrementar mi formación profesional
-
Me gustaría tomar clases de fotografía, ya que me llama mucho la atenció
-
Realizar un intercampus en campus Querétaro o en campus Monterrey
-
Investigación de proyecto para tener la oportunidad de publicar un articulo científico
-
Iniciar mis practicas profesionales en empresas como Sanofi, Unilever, Pfyzer.
-
Obtener mi titulo profesional en el Tecnológico de Monterrey con especialidad en bioprocesos
-
Trabajar en una empresa que tenga un impacto mundial y global e ir escalando diferentes rangos para superarme profesionalmente.
-
Encontrar un trabajo estable, realizar investigaciones y poder tener una casa o un departamento e irme a vivir a otro estado de la Republica o vivir en otro país.
Looking for a timeline maker?
Create timelines for projects, roadmaps, history, lessons, legal cases, and stories with Timetoast. Timetoast is a timeline maker for work, school, research, and stories.